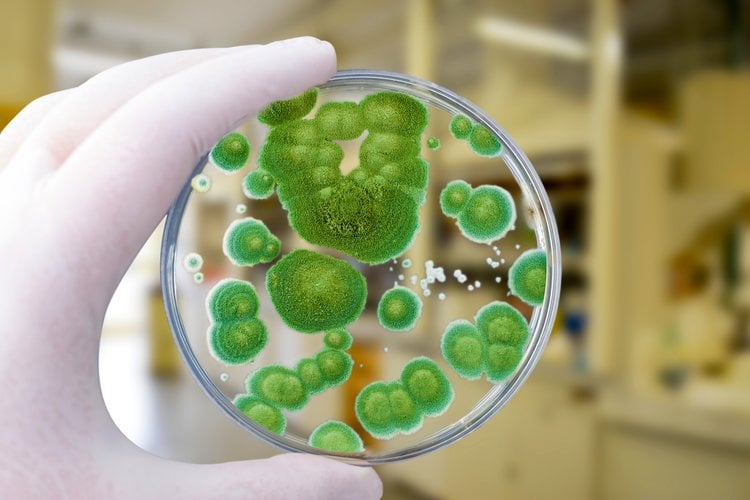

Moulds and shelf-life
Moulds consume valuable nutrients in raw materials and feed, and if allowed to proliferate, can rapidly decrease the products’ shelf life, quality and nutritional value. Additionally, the mycotoxins produced by moulds may negatively impact animal performance. If not addressed properly, it can result in a significantly negative impact on finances and brand reputation.
Raw materials can account for up to 80% of total feed production cost, and so it is vital to prevent mould growth that results in loss of volume (shrinkage) or nutritional value. It’s also important to note that the common practice of adding water to compensate for moisture loss during the feed production process increases the risk of mould and compromises the shelf life of feed.
Moulds destabilise the integrity of the feed materials, which opens up an opportunity for other harmful microorganisms such as yeasts and bacteria to grow and proliferate. Producing stable, high-quality feeds efficiently and profitably requires an integrated solution that includes appropriate products, effective dosing, and analytic services that fit the specific circumstances and type of feed.

Salmonella control
Feed, as a source of Salmonella, is under constant monitoring due to the contamination risks it brings to the feed-to-food chain.
Processing conditions during pelletising and extrusion are key to inactivating Salmonella. However, heat treatment does not protect feed from post-processing contamination, as it offers no residual effect. Additionally, a temperature drop right after cooling may lead to condensation, which provides favourable conditions for Salmonella to proliferate.
This contamination can occur post-processing, in the feed mill, or during storage, transport and handling. Placing Salmonella-contaminated feed in the market, has negative consequences for the business operation of a feed miller, leading to economic losses and affecting their customers.
To avoid these issues, feed mill customers prefer to work with certified suppliers who are committed to delivering Salmonella-safe feed. A fully integrated and holistic approach is needed, including plant audits, analytical services, effective dosing of treatment product and regular evaluation.